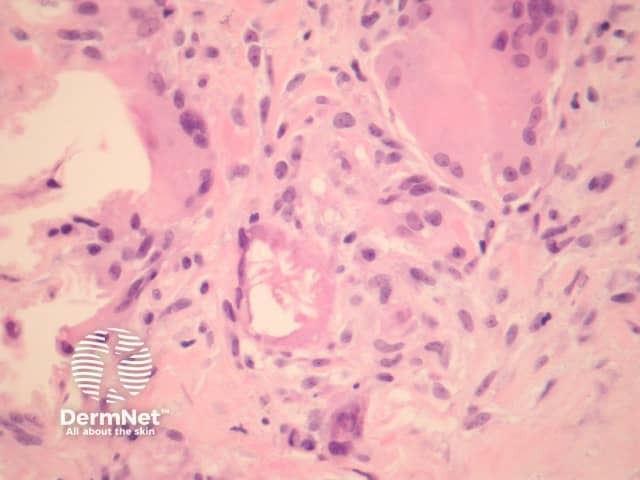
Figure 4

Main menu
Common skin conditions
NEWS
Join DermNet PRO
Read more
Quick links
Systemic diseases Diagnosis and testing
Author: Assoc Prof Patrick Emanuel, Dermatopathologist, Auckland, New Zealand. January 2015.
Erythema nodosum is the most common form of panniculitis. It typically presents as tender, erythematous, subcutaneous nodules and plaques, arising in crops most commonly on the pretibial areas bilaterally.
Erythema nodosum histologically represents the prototype of a septal panniculitis. The classic histopathologic presentation of erythema nodosum is that of a septal panniculitis with a mixed cellular infiltrate of lymphocytes, histiocytes, giant cells, and occasional eosinophils and a characteristic absence of vasculitis (figures 1-3).
Miescher's radial granulomata that consist of small nodules composed of spindle to oval-shaped histiocytes arranged around minute slits are thought to be a relatively specific finding for erythema nodosum (figure 4).
Early lesions may be difficult to diagnose on histopathologic features alone. Sections may show oedematous septa containing a prominent mixed inflammatory infiltrate, and minimal fibrosis. As the lesions evolve, there is neutrophilic infiltration followed by chronic infiltrates, granulomas and septal fibrosis.
Small vessel vasculitis (or venulitis) may be seen in early lesions.

Figure 1

Figure 2

Figure 3
Figure 4
None are are generally needed. Heavy neutrophilic infiltrates may prompt staining for microorganisms.
Early lesions may resemble neutrophilic dermatoses.
Late lesions may resemble other causes for sclerosis of the subcutis, including resolving fat necrosis, dermatitis artefacta, and lipodermatosclerosis.
Miescher radial granulomata have also been described in erythema induratum, necrobiosis lipoidica, Sweet syndrome and Behçet disease.